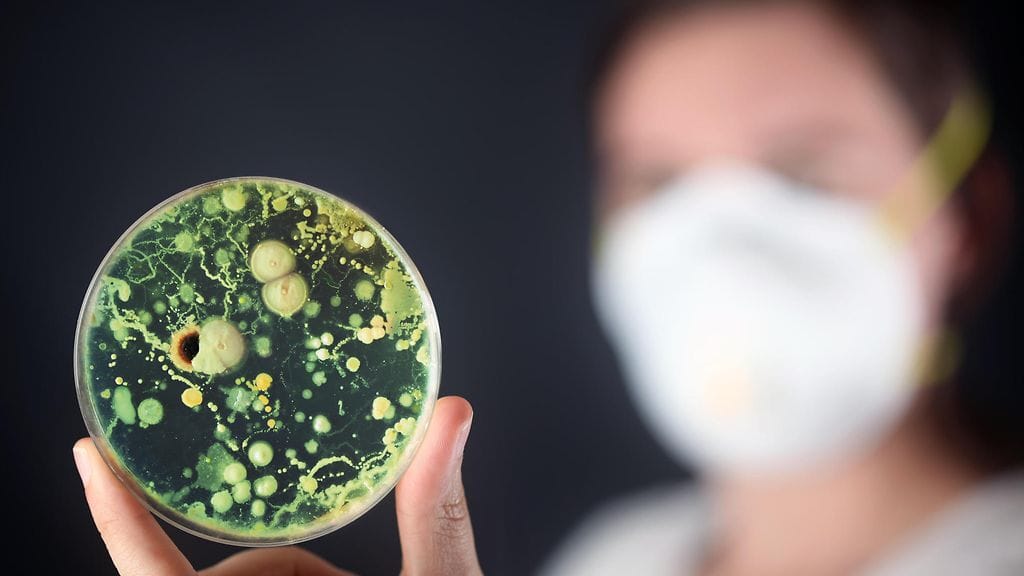
Ruotsin kansanterveysvirasto kertoo uudesta tutkimuksesta, jonka mukaan vastustuskykyisempien bakteerikantojen määrät ovat nousseet vauhdilla.

Useille lääkkeille vastustuskykyinen E. coli -bakteerikanta on leviämässä huolestuttavaa vauhtia Euroopassa, tiedottaa Ruotsin kansanterveysvirasto.
Ruotsin kansanterveysvirasto kertoo uudesta tutkimuksesta, jonka mukaan vastustuskykyisempien bakteerikantojen määrät ovat nousseet voimalla viime vuosien aikana myös Ruotsissa.
Euroopan tautien ehkäisy- ja valvontakeskus (ECDC) on yhteistyössä eri tahojen kanssa osoittanut, miten lääkeresistentit bakteerit ovat levinneet Euroopan maiden sisällä ja niiden välillä. Tutkimus on julkaistu Eurosurveillance-julkaisussa.
Tutkija Vilhelm Müller Ruotsin kansanterveysvirastosta toteaa, että tutkimus on uusi todiste moniresistenttien bakteerien vakavasta yleistymisestä, joka uhkaa heikentää kykyä hoitaa vakavia bakteeri-infektioita tulevaisuudessa.
– Tarvitsemme kiireellisiä toimia antibiooteille vastustuskykyisten bakteerien leviämisen estämiseksi Ruotsissa ja maailmanlaajuisesti, hän toteaa.
Tutkittu kanta on yleinen syy muun muassa virtsatieinfektioihin ja sepsikseen. Korkean vastustuskykynsä takia kyseisiä infektioita sairastaville potilaille on jäljellä vain muutamia hoitovaihtoehtoja.
Tutkimuksessa korostetaan, että on tärkeää kehittää ja parantaa edelleen edellytyksiä lääkkeille vastustuskykyisten bakteerien leviämisen vähentämiseksi